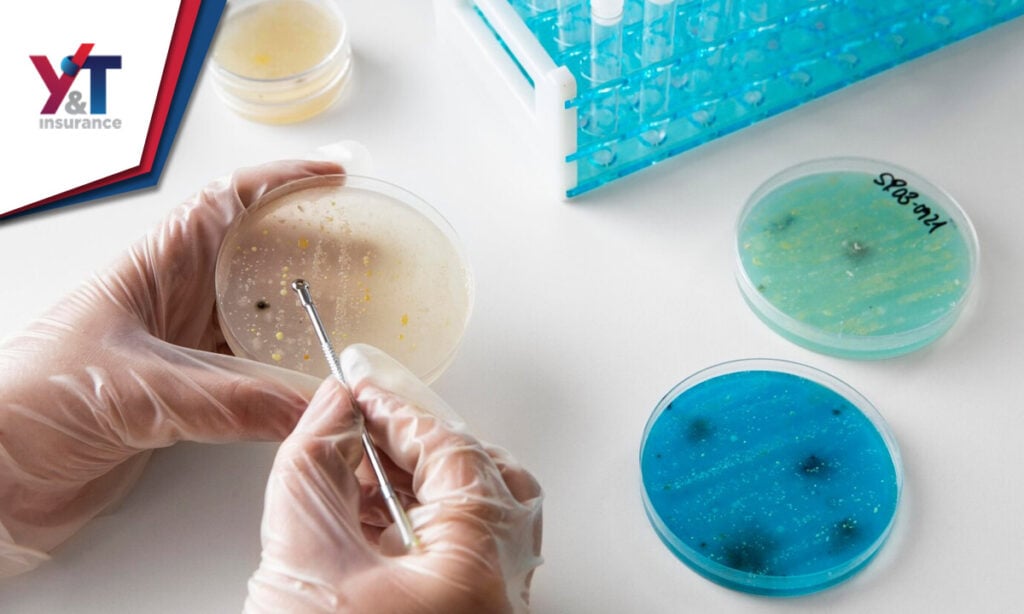
Seguros que cubren Fertilización in Vitro en Estados Unidos

Seguros que cubren Fertilización in Vitro en Estados Unidos (Florida)
Los Seguros Médicos en Estados Unidos tienen una relación complicada con los tratamientos de fertilidad, como la inseminación in vitro. En este artículo abordo esta relación.
Consulté las mejores fuentes, y trato de hacer un análisis objetivo del tema. El objetivo es brindarte información confiable para que puedas tomar la mejor decisión con todas las cartas sobre la mesa.
La Inseminación in Vitro y los Seguros Médicos
En Estados Unidos, 15 Estados tienen leyes que exigen a las empresas aseguradoras cubrir la Fertilización In Vitro (FIV). Los Estados que cubren la FIV son: Arkansas, Connecticut, Delaware, Hawai, Illinois, Luisiana, Maryland, Massachusetts, Montana, Nuevo Hampshire, New Jersey, Nueva York, Ohio, Rhode Island, Virginia del Oeste.

La Inseminación in Vitro no está incluida en muchos de los Seguros de Salud estándar que se comercializan en el mercado de Seguros en la Florida. Esto puede resultar un drama para las familias que necesitan asistencia en su proceso de procreación.
Considera que los servicios médicos relacionados con la reproducción suelen ser caros. Por ejemplo, la Sociedad Estadounidense de Medicina Reproductiva estima que el costo promedio de la Fertilización In Vitro (FIV) es de $12,400. Sin embargo, el número final puede variar mucho de acuerdo a las particularidades de cada caso.
Además, personas que se someten a un tratamiento de inseminación in vitro también pueden pagar tarifas adicionales por las pruebas genéticas de embriones y las pruebas de diagnóstico. Estas pruebas pueden sumar facturas que superan fácilmente entre $ 1,200 y $ 1,700.
Es cierto que los seguros médicos pueden ayudar con algunos de los procedimientos, pero difícilmente le van a cubrir todos los costos de la Inseminación. Por ejemplo, algunas pruebas de laboratorio, en la etapa diagnostica, pueden ser cubiertas dentro de los beneficios del plan de salud.
En los casos donde el ovulo proviene de una donante diferente, es posible que se sumen costo de atención y medicamentos para esa persona. Los Seguros Médicos regulares, disponibles a través de planes del gobierno en Florida, no cubren ninguno de estos acápites. Según datos publicados en por KFF, en estos casos los costos de la FIV pueden escalar hasta los 72 mil dólares.

¿ObamaCare cubre la Fecundación in Vitro?
Bajo la ley de ObamaCare la Inseminación in Vitro no está cubierta, porque la salud reproductiva no es una prioridad. Los tratamientos de fertilidad, como los procedimientos in vitro, y otros por el estilo, están excluidos de los 10 beneficios esenciales de Obamacare.
Hasta la actualidad, no conozco un programa de salud gubernamental que cubra la Inseminación en Florida. No puedo recomendar un Seguro Médico, bajo ObamaCare que le asegure a la cobertura de la Fertilización in Vitro en este Estado.
La cobertura de los Seguros de Salud contratados bajo ObamaCare se limitan a la etapa de embarazo, parto y post parto. Sin embargo, como quedó expresado anteriormente, la asistencia al proceso para tratar o estimular la fertilidad no están comprendidos dentro de la Ley ACA.
¿Qué Seguros de Salud cubren la Inseminación in Vitro en Florida?
En la Florida existen Seguros de Salud privados que cubren la Fertilización in Vitro. Sin embargo, al momento de buscar cobertura para la FIV debes partir por identificar la clínica o institución médica donde recibirás los tratamientos.
Entre las clínicas o centro que ofrecen Fertilización in Vitro, podemos destacar la IVF Florida y la Fertility Center Miami. Estas instituciones trabajan con varias aseguradoras, que ofrecen las coberturas necesarias.
Entre los Seguros que cubren tratamientos de fertilidad, según información brindada por las clínicas mencionadas, podemos encontrar:
- Aetna® (Todos Los Productos)
- AvMed
- Blue Cross® Y Blue Shield® (HMO, PPO, POS)
- RedAzul
- Opciones De Salud™
- Tradicional
- Atención Preferida Al Paciente
- Cigna® (Todos Los Productos)
- Coventry (Todos Los Productos Para Servicios De Infertilidad Únicamente)
- First Health Network
- Golden Rule UHC
- Humana ® (Solo Contratado Para La Visita Inicial De Un Nuevo Paciente)
- Memorial Managed Care (HMO, PPO, PHO)
- UnitedHealthcare ® (Todos Los Productos)
- United Resource Networks (URN)
- Pasos Para Padres
- Servicios De Recursos Reproductivos
Otras alternativas en los Tratamientos de Fertilidad
Si tu Seguro de Salud no se encuentra dentro de la lista anterior, puedes explorar otras vías o alternativas para financiar la fertilización in Vitro. Estas vías no están abiertas a todas las personas, ya que en muchas necesitarán demostrar estabilidad financiera para acceder a las alternativas.
Las dos alternativas reconocidas son:
Apelar a una variedad de tratamiento de Fertilidad de dosis baja
La FIV de dosis baja, también conocida como FIV de estimulación mínima, es menos costosa que el procedimiento de Inseminación estándar. Este tratamiento reduce la utilización de la medicación hormonal, lo que abarata los costos, pero también reduce la tasa de éxito.
La FIV de dosis baja puede ser una alternativa para aquellas personas con fertilidad reducida, pero que aún conservan algo de capacidad reproductiva. La edad es un factor clave en este tipo de tratamiento, siendo más recomendable en mujeres menores de 35 años.
En aquellos casos donde la Fertilización suave (FIV de dosis baja) no es posible, entonces la alternativa se encamina al ámbito economivo.
Buscar asistencia financiera para cubrir los costos de atención privada
La siguiente alternativa es buscar un financista que cubra los costosos procedimientos de Fertilización in Vitro. Algunos Centro de salud ya trabajan con financieras específicas, que ofrecen sus servicios para cubrir estos procedimientos u otros que no están contemplados en los planes de salud estándar. Puede preguntar en su clínica o centro de salud si pueden ofrecerle una opción como esta.
En este caso, tiene que considerar la cantidad de dinero que está dispuesto a gastar, sin que exista garantía de éxito. Debería hablar con sus doctor o doctora, para que le facilite estadísticas basadas en su edad y factores médicos relevantes de su caso. Esta información, ayudará a evaluar si quiere asumir el riesgo financiero que implica un préstamo, para financiar su FIV.
¿Le sirvió este contenido sobre la Fertilización in Vitro en la Florida?
Espero que toda la información compartida sea de ayuda para tomar las mejores decisiones con respecto a si es una opción o no practicarse una Fertilización in Vitro. Si está buscando tener hijos, le deseamos la mejor de las suertes, para que pueda alcanzar ese sueño o meta familiar.
Si realmente fue de ayuda el contenido, comparte en tus redes sociales para que llegue a otras mujeres que podrían estar en la misma situación. Ellas y nosotros se lo agradeceremos de corazón.
PREGUNTAS FRECUENTES
¿Qué es la Inseminación o Fecundación in Vitro (FIV)?
La fecundación in vitro es un procedimiento de reproducción asistida utilizado para la concepción en pacientes con problemas de fertilidad. Consiste en la recolección de óvulos maduros de los ovarios que se fecundan con espermatozoides en un laboratorio.
Los óvulos fecundados se implantan en un útero, siendo esta la forma más efectiva para engendrar a través de los procedimientos de reproducción asistida. Se pueden utilizar tus propios óvulos y los espermatozoides de tu pareja o también los óvulos y esperma de donantes anónimos.
No son comunes los Seguros Médicos que cubren reproduccion asistida en Florida.
¿Cómo funciona la Fertilización in Vitro?
A continuación, se describe de manera general cómo funciona la FIV:
- Estimulación ovárica: En primer lugar, la mujer que se somete a FIV recibe medicamentos para estimular la producción de múltiples óvulos en sus ovarios en lugar de uno solo, como ocurre en un ciclo natural. Esto se hace para aumentar las posibilidades de éxito. El proceso de estimulación ovárica se controla de cerca mediante ecografías y análisis de sangre.
- Recolección de óvulos: Una vez que los folículos (estructuras que contienen los óvulos) alcanzan el tamaño adecuado, se realiza una punción ovárica bajo anestesia para extraer los óvulos. Este procedimiento se llama aspiración folicular y se realiza mediante una aguja guiada por ecografía.
- Obtención de espermatozoides: Mientras se están recolectando los óvulos, se obtienen los espermatozoides del donante o de la pareja masculina. Estos espermatozoides pueden ser procesados y preparados para la fertilización.
- Fertilización: Los óvulos y los espermatozoides se combinan en el laboratorio en una placa de cultivo o un tubo de ensayo. Este proceso puede realizarse de dos maneras:
- Fertilización convencional: En este método, los espermatozoides se colocan cerca de los óvulos y se espera que la fertilización ocurra de manera natural.
- Inyección intracitoplasmática de espermatozoides (ICSI): En este enfoque, un espermatozoide se inyecta directamente en un óvulo. Se utiliza cuando hay problemas de fertilización previos o cuando se necesita un alto grado de control sobre el proceso de fertilización.
- Cultivo embrionario: Después de la fertilización, los embriones resultantes se colocan en un incubador y se monitorean cuidadosamente mientras se desarrollan durante varios días. El objetivo es permitir que los embriones alcancen un estado de desarrollo adecuado antes de la transferencia al útero.
- Transferencia de embriones: Uno o varios embriones se seleccionan para ser transferidos al útero de la mujer, generalmente entre 3 y 5 días después de la fecundación. La transferencia se realiza a través de un catéter que se introduce en el cuello uterino.
- Congelación de embriones: Si se obtienen embriones adicionales de buena calidad durante el proceso de FIV, pueden ser congelados para su uso en ciclos futuros.
- Prueba de embarazo: Después de unos días o semanas de la transferencia de embriones, se realiza una prueba de embarazo para determinar si la FIV ha tenido éxito.
Es importante destacar que la FIV es un procedimiento complejo que requiere supervisión médica y un equipo de profesionales de la salud altamente capacitado.
¿Cuál es la Tasas de éxito de la Fertilización in Vitro en Estados Unidos?
La Tasa de éxito en los procesos de Inseminación in Vitro varían de acuerdo a factores como la edad, la existencia de enfermedades preexistentes, y la cantidad de intentos de fertilización realizados. De acuerdo a cifras divulgadas por el CDC, las mujeres menores de 35 años alcanzan una tasa de éxito del 55%. Para las mujeres que superan esta edad, los procedimientos satisfactorios se reducen en un 8 por ciento.
¿Los seguros médicos ofrecidos por el Estado cubre la Fecundación in Vitro?
Los Seguros y Planes médicos ofrecidos por el estado de la Florida NO cubre la totalidad de los costos de una Fecundación in Vitro. Es cierto que algunas pruebas diagnósticas pueden quedar bajo la sombrilla del Obamacare, pero su cobertura es muy limitada.
